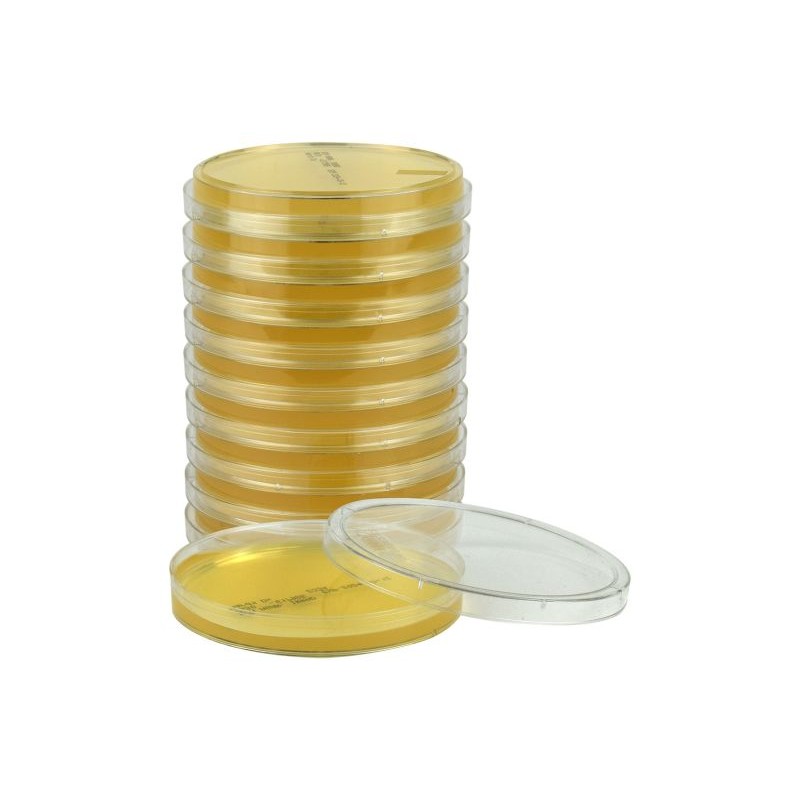
SterEM™ Gélose R2A, USP, irradié, triple emballage

- +Produits
- +Consommables de laboratoire
- +Équipement de laboratoire
- +Équipement pour la microbiologie
- +Milieux de Culture - réactifs et trousses de performance
- +Solutions de sécurité alimentaire Neogen®
- +Systèmes de surveillance des températures et de l'humidité
- +Tests d'allergènes
- +Tests environnementaux
- +Services
- SUPPORT
- Nouvelles
- +À propos de nous
- Contact




SterEM™ Gélose R2A, USP, irradié, triple emballage
La gélose R2A irradiée est recommandée pour le dénombrement des bactéries hétérotrophes dans l'eau, en particulier l'eau potable.
Les plaques sont conditionnées dans un triple emballage et stérilisées par irradiation afin d'assurer un niveau de stérilité plus élevé.
Caractéristiques et avantages :
Triple emballage - Sac extérieur et sac intermédiaire en PET transparent pour une visualisation sans distorsion, sac intérieur transparent respirant.
Les boîtes de Pétri en polystyrène sont dotées d'anneaux en relief pour faciliter l'empilage et empêcher le glissement.
Stérilisées par irradiation, validées pour un niveau d'assurance de stérilité (Sterility Assurance Level ou SAL) de 10-6.
Le certificat d'analyse est disponible 24 heures sur 24 et 7 jours sur 7 sur le site web de Hardy Diagnostics.
Fabriquées dans une usine cGMP agréée, dotée d'un système de gestion de la qualité certifié ISO 13485.
Téléchargement